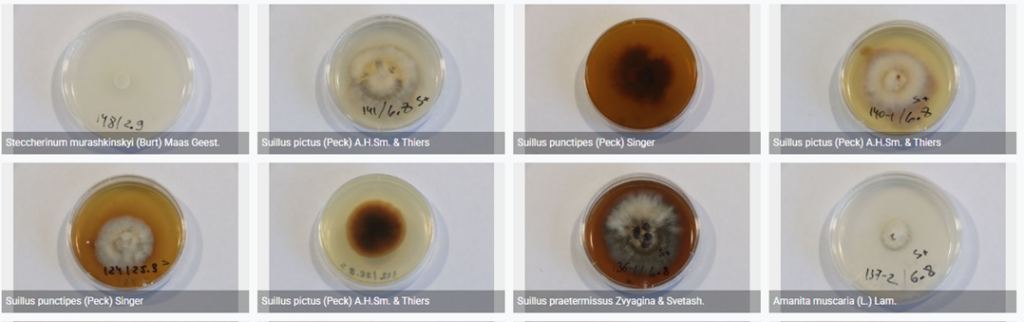

Fungal Culture Collection of Yugra State University
The YSU-C is the living fungal culture collection of the Yugra State University Fungarium. It serves as a vital repository for the mycobiota of Western Siberia, with a special focus on unique ecosystems like ombrotrophic bogs and coniferous forests.

Collection Overview & Purpose
This collection of approximately 250 strains of basidiomycetes and ascomycetes is a multifaceted resource designed to support:
- Taxonomic & Biodiversity Research, providing verified reference material for studying regional fungal diversity.
- Biotechnological Application, serving as a source of strains for developing mycorrhizal inoculants, bioremediation agents, and products for medicine and nutrition.
- Ecological Studies, enabling research into the functional roles of fungi in boreal and peatland ecosystems.
- Education & Genetic Repository, supporting student training and preserving genetic diversity for the global scientific community.
Collection Scope & Key Groups
The collection is ecologically and biotechnologically diverse. Key groups include:
- Ectomycorrhizal Fungi — candidates for developing inoculants to enhance tree growth and forest restoration.
- Peatland Saprotrophs — with potential applications in wetland bioremediation and peat-based fertilizers.
- Medicinal Fungi — including species like Ganoderma and Hericium, relevant for dietary supplements and pharmaceuticals.
- Edible & Cultivated Mushrooms — strains of Pleurotus, Lentinula, and others.
- Wild Macromycetes & Microfungi — documenting the region’s diversity, including rare and protected species.
Primary Geographic Coverage: Khanty-Mansiysk district, Khanty-Mansi Autonomous Okrug–Yugra, Russia (e.g., Shapsha vicinity, Mukhrino Field Station).
Taxonomic Coverage: about 80 genera, with well-represented groups including Suillus, Amanita, Hypholoma, Pleurotus, and Penicillium.
Collection Management
- Primarily isolated from fruiting body tissue, with additional strains from substrates and root tips.
- Maintained by subculturing on agar media. Saprotrophs are stored at +5°C, while ectomycorrhizal strains are kept at room temperature.
- Each strain is morphologically described. For most, identification is confirmed via DNA barcoding (ITS region sequencing) and BLAST analysis.
- All data (locality, storage conditions, sequences, photographs) are managed in the Specify database system and published as a Darwin Core Archive on GBIF.
YSU Culture Collection catalog of MYCORRHIZAL STRAINS (Excel table download)
YSU Culture Collection catalog TOTAL (incl different biotech modes, saprotrophs etc.) (vill be available soon)
Visit full YSU-C collection database via GBIF dataset (including photographis of cultures and related sequences)
Last update 04/02/2026
